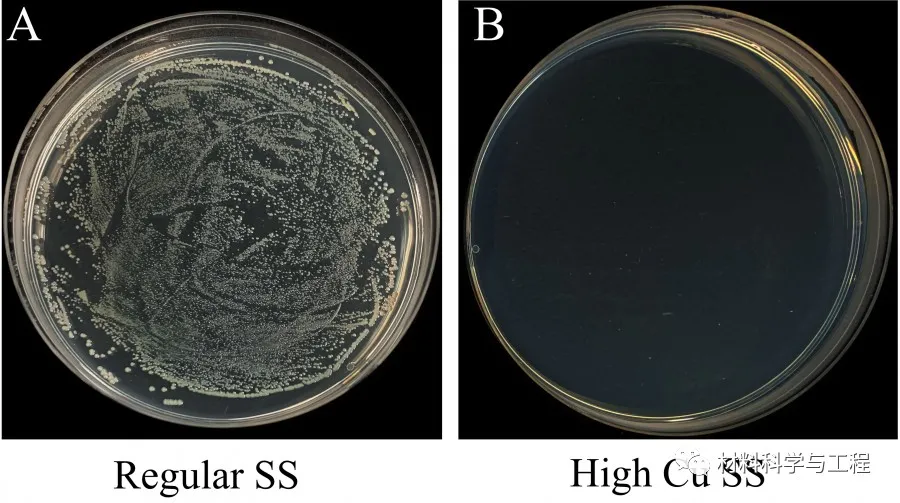
640?wx_fmt=jpeg&tp=webp&wxfrom=5&wx_lazy=1&wx_co=1.jpg

不锈钢是公共卫生领域使用最为广泛的物料之一,但其本身并无抗击有害微生物的特性。早前的研究显示,新型冠状病毒(SARS-Cov-2)在常规的不锈钢表面有很强的稳定性,残留在不锈钢表面,在长达三天后仍然具感染性,让病毒有机会在公众场所透过接触传播。
香港大学(港大)工程学院机械工程系黄明欣教授领导的团队,与港大李嘉诚医学院免疫与感染研究中心潘烈文教授的研究团队合作,研发出高铜含量不锈钢,能成功杀灭存留于其表面的新冠病毒、甲型流感病毒以及大肠杆菌,是全球已知首个其自身表面可杀灭新冠病毒的不锈钢。

研究成果已于11月25日在学术期刊《化学工程杂志》(Chemical Engineering Journal)发表,论文题为『可抗击新冠病毒的抗病原体不锈钢』(“Anti-pathogen stainless steel combating COVID-19”)。
"今次的研究成果非常重要,是全球首个其自身表面可以杀灭新冠病毒的不锈钢。"黄明欣教授说。
黄教授进一步解释说:今次的研究,团队通过调整不锈钢的化学成分和微观组织结构,成功令不锈钢表面可以杀灭新冠病毒和其他常见的病原体微生物。研究又发现,新型冠状病毒和甲型流感病毒在纯铜和高铜不锈钢(例如,≧ 10 wt%)的表面会快速被杀灭,在纯银和低铜不锈钢(例如,≦5wt%)表面却表现出良好的稳定性。研究结果显示了利用银和铜作为开发抗病原体不锈钢的合金添加元素存在的差异。
团队研发的抗新冠病毒不锈钢正在申请国际专利。目前团队正计划与工业界合作,利用新不锈钢制备一些在公共场所中应用广泛的不锈钢电梯按钮、门把手和扶手等的原型作测试,有望进一步把研发成果工业化生产和商品化。研究团队已利用高铜不锈钢(20wt%)制备电梯按钮,作为生产测试之用。
「大量的富铜析出相,均匀地弥散在整块不锈钢中。因此,不锈钢的表面即使不断受到磨损或破坏,它依然可以持续地杀灭表面存留的病原体微生物。」论文第一作者、黄明欣教授的博士生刘立涛先生说。
「当前开发的抗新冠病毒不锈钢可以使用现有成熟的工业技术进行批量生产。相关产品可用于替换公共场所中一些频繁接触的常规不锈钢产品,以降低公众感染的风险,对抗当前的新冠疫情。」黄教授补充说。
团队在《化学工程杂志》发表,题为《可抗击新冠病毒的抗病原体不锈钢》的论文连结。DOI:10.1016/j.cej.2021.133783
免责声明:本网站所转载的文字、图片与视频资料版权归原创作者所有,如果涉及侵权,请第一时间联系本网删除。
官方微信
《中国腐蚀与防护网电子期刊》征订启事
- 投稿联系:编辑部
- 电话:010-62316606-806
- 邮箱:fsfhzy666@163.com
- 中国腐蚀与防护网官方QQ群:140808414



